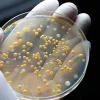
Article Thumbnail

Dorinel Umbrărescu este cel mai important constructor de autostrăzi și drumuri din țara noastră, el primind astfel supranumele de „regele asfaltului”. În ciuda faptului că are în derulare lucrări la mai multe șosele importante, compania controlată de afaceristul băcăuan a intrat și în cursa pentru proiectarea și execuția lotului Joseni-Ditrău din Autostrada A8 Târgu Mureș - Târgu Neamț.
Companiile controlate de omul de afaceri Dorinel Umbrărescu sunt implicate în prezent în relizarea mai multor autostrăzi importante din țara noastră. Regele asfaltului nu se oprește însă aici, un nou proiect de anvergură intrând pe lista sa de priorități.
Un nou proiect de anvergură vizat de compania lui Dorinel Umbrărescu
Este vorba despre lotul Joseni – Ditrău, în lungime de 14,4 kilometri, al Autostrăzii A8 Târgu Mureș – Târgu Neamț. La licitația pentru proiectarea și execuția acestui tronson, Compania Națională de Investiții Rutiere a primit cinci oferte. Printre firmele înscrise se numără și grupul UMB Tehnostrade, controlat de Dorinel Umbrărescu. Termenul limită pentru depunerea ofertelor este data de 15 ianuarie 2025.
Iată care sunt cele cinci companii ce au depus oferte în cadrul licitației pentru proiectarea și execuția lotului Joseni – Ditrău al Autostrăzii A8 Târgu Mureș – Târgu Neamț:
Nurol Insaat ve Ticaret (Turcia) Ofertant Unic;
Geiger Transilvania (România) Ofertant Unic;
Asocierea Danlin XXL (Leader/România) -Groma Hold-Intertranscom Impex SRL;
Asocierea MIS Grup (Leader/România)-Ad Astra IPP SRL- Automagistral-Pivden LLC;
Asocierea SA&PE Construct SRL (Leader)-Spedition UMB-Tehnostrade SRL (România).
Valoarea totală estimată pentru relizarea lotului Joseni – Ditrău este de aproximativ 1,2 miliarde de lei (fără TVA). Durata de relizare este de 34 de luni, din care 10 luni pentru proiectare și 24 de luni pentru execuție. De asemenea, perioada de garanție este de 5 ani.
Ce lucrări implică tronsonul Joseni-Ditrău al Autostrăzii A8
Lotul 1D Joseni –Ditrău are o lungime de 14,4 kilometri, pe traseul său fiind prevăzute 21 de pasaje și viaducte, dintre care 3 sunt pasaje tip ecoducte pentru permeabilitatea animalelor, dar și un nod rutier la Joseni.
Totodată, pe acest lot va fi amenajat câte un spațiu de servicii (stânga/dreapta) tip S1, care include zonă comercială, benzinării, 12 spații de încărcare pentru mașini electrice și toalete. În plus, pentru asigurarea funcționalității indepndente a lotului Joseni - Ditrău, contractul prevede și realizarea unei descărcări provizorii în zona de conexiune cu următorul lot (2A Ditrău-Grințieș).
Secțiunea de munte Sărățeni-Pipirig din cadrul A 8 are o lungime de 116 kilometri și include patru loturi:
Lotul 1C Sărățeni-Joseni (32,4 kilometri);
Lotul 1D Joseni-Ditrău (14,4 kilometri);
Lotul 2A Ditrău-Grințieș (37,9 kilometri);
Lotul 2B Grințieș-Pipirig (31,5 kilometri).